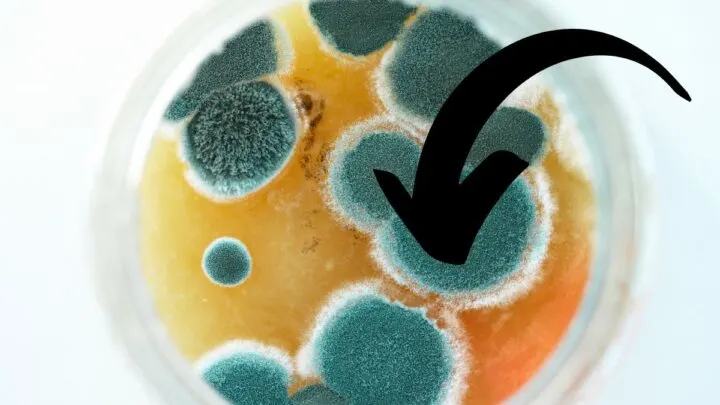
Can Paint Get Moldy?

Mold is a fungus that grows in damp, dark places. But can paint itself get moldy?
Mold and mildew have a terrible rep for being dangerous, unattractive, unsightly, and messy.
Before a paint job, you must remove any apparent mold growth. Even if you apply mold-inhibiting paint, the mold will continue to be an issue.
Paint can get moldy. Since mold is a fungus that thrives in environments with moisture, paint is also susceptible to its growth. Mold-resistant paint can help prevent mold growth, but it won’t be able to stop it once it’s started.
Painting over mold will hide the black spots where it is forming, but it will not solve the problem.
Mold can be painted over, but if it isn’t stopped in its tracks, it will always reemerge. Mold can cause many health and respiratory problems in both animals and humans.
We have carefully put together this guide to help you learn more about the effects of mold on paint and if paint is susceptible to mold. Let’s get started!
Can Paint Get Moldy?
The most effective technique to get rid of mold is to avoid the conditions that lead to it in the first place.
However, if you have a mold problem, you must eliminate all mold spores. The first step is to identify where the extra moisture is coming from and take steps to fix it before cleaning in order to kill the mold.
If the mold is growing in a constantly damp place or if it covers a significant area, contact a professional to help you with the problem.
Always wipe away any mold that has dried on the surface using a cloth. Then get ready for a thorough cleaning.
While bleach has been the go-to chemical for years and is incredibly cost-effective, it only kills mold on the surface.
It will totally destroy the fungus on rough surfaces, making it an excellent option for window frames and other similar applications.
When it comes to wood painting, bleach will only address the surface issue, not a deeper issue caused by moisture.
Homeowners can purchase bleach that has 95% water and only 5% chlorine to help with this problem.
Do not use a wet paint container if mold forms within it.
Getting rid of any rotten paint is a good idea. Some communities have laws governing how paint should be disposed of.

What Happens If Moldy Paint Is Used?
Painting over mold doesn’t fix the problem – it only hides it.
The moldy patch will continue to grow even after the paint has dried.
Mold will continue to grow if left untreated, eventually requiring the removal and replacement of the entire ceiling or wall.
Removing Mold from Paint
- Combine two tablespoons borax, 1/4 cup white vinegar, and two cups boiling water in a mixing basin.
- Fill a spray container halfway with the mixture.
- Paints should be used sparingly.
- Spray again after scrubbing and wiping and let sit for 10 minutes before wiping.
How Do You Know If Your Paint Is Bad?
Paint that has a sour, nasty, or rotten odor after opening is an indication for mold-infested paint.
It’s possible that paint that smells like mold or mildew isn’t the same as other paints.
If the paint is applied, the scent may reduce, but not completely disappear, and it may harm your walls in the long-run.
What Happens If Mold Is Used With Paint?
The paint will chip, flake, and bubble if you paint over mold, suggesting that the mold is still present.
You will just prolong the problem and cover it for a short time if you paint over it. Do not use a wet paint container if mold forms over it.
Getting rid of any rotten paint is a good idea. Some communities have laws governing how paint should be disposed to avoid health issues.
What Happens If You Use Moldy Paint?
A poor paint job with bad or mold-infested latex paint can cause an unpleasant odor to develop.
A faulty latex paint job can also leave a noticeable rough finish on the painted walls, which can easily peel off and make them appear worse than ever.
In addition, moldy paint fumes can have both short-term and long-term health consequences.
When paint is applied and then cured, it might cause breathing difficulties, dizziness, watery eyes, and headaches.
There are additional issues with throat irritation and vision impairment in addition to these initial symptoms.

How Can Mold Be Removed From Paint?
A solution of 1 part bleach to 2 parts water should be used in a spray bottle to remove mold.
The combination should be applied to the affected area with a spray bottle. Rinse the spray container with water filled with the spray after 10 minutes.
Moreover, you can also use vinegar to get rid of mold. Vinegar is a gently acidic cleansing, deodorizing, and disinfecting agent.
On permeable and non-permeable surfaces, vinegar has the ability to eliminate 80% of mold species, including black mold.
Allow an hour to pass after spraying the vinegar on the moldy surface. The last step is to clean the area with water and allow it to dry.
What happens if mold is painted over? Painting over mold will not kill it or prevent it from growing again.
Mold can cause nose skin and eye irritation, wheezing or coughing, throat irritation, stuffiness, and more severe reactions in persons with impaired immune systems, according to the CDC.
Is Mold Killing Paint Available?
Mold killing primer comes with a water-based defensive coating that can be used to coat over existing odor-causing bacteria, fungi, moss, mildew, mold, and other fungal organisms and destroy them.
Mold, mildew, and odor are no longer present.
Paint that stinks or has an unpleasant odor should be thrown away immediately without a second thought.
Most latex paints have a shelf life of up to ten years; however, paint can easily develop mold in a considerably shorter time if not maintained properly.
Therefore, if the paint is moldy on top, it should be discarded right away.
How to Check Moldy Paint
Use a screwdriver to open the lid of the paint can. The can is packed with gases that provide a strong chemical odor when the paint is good and still useful.
When paint emits a strong putrid stench, it has gone bad. The basic line is that painting over mold will not eliminate it.
Using mold-resistant paint or adding mold inhibitors to your paints is a possible approach for preventing mold growth.
Summing Up If Paint Gets Moldy
It’s important to remember that paint does not kill mold.
Therefore, painting over the black patches where mold is forming may temporarily hide the problem, but it will not solve it.
Mold-resistant paint will keep mold from growing, but it will not kill it once it has sprouted. Mold can be painted over, but if you don’t stop it, it will always recur.
Make sure you get rid of the problem itself before painting over mold or using moldy paint.